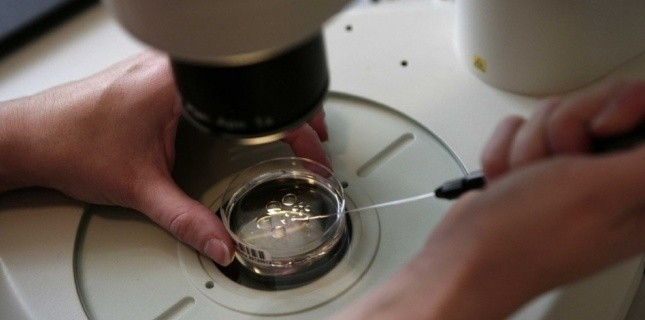

L'initiative n'a pas convaincu, les jeunes femmes qui appelaient notamment à l'ouverture de la PMA pour toutes, ont rapidement été repoussées.
Étiquette : dons de sperme
L’Autriche accorde aux couple homosexuels l’égalité des droits devant l’adoption
Les conjoints homosexuels autrichiens pourront désormais adopter des enfants dans les mêmes conditions que les couples hétérosexuels.
Les dons de sperme en baisse parce que les revendications LGBT ?
Il n’y a plus que 200 donneurs de sperme en France contre le double en 2009. Le Pr Jean-François Guérin, responsable du Cecos de Lyon, explique...